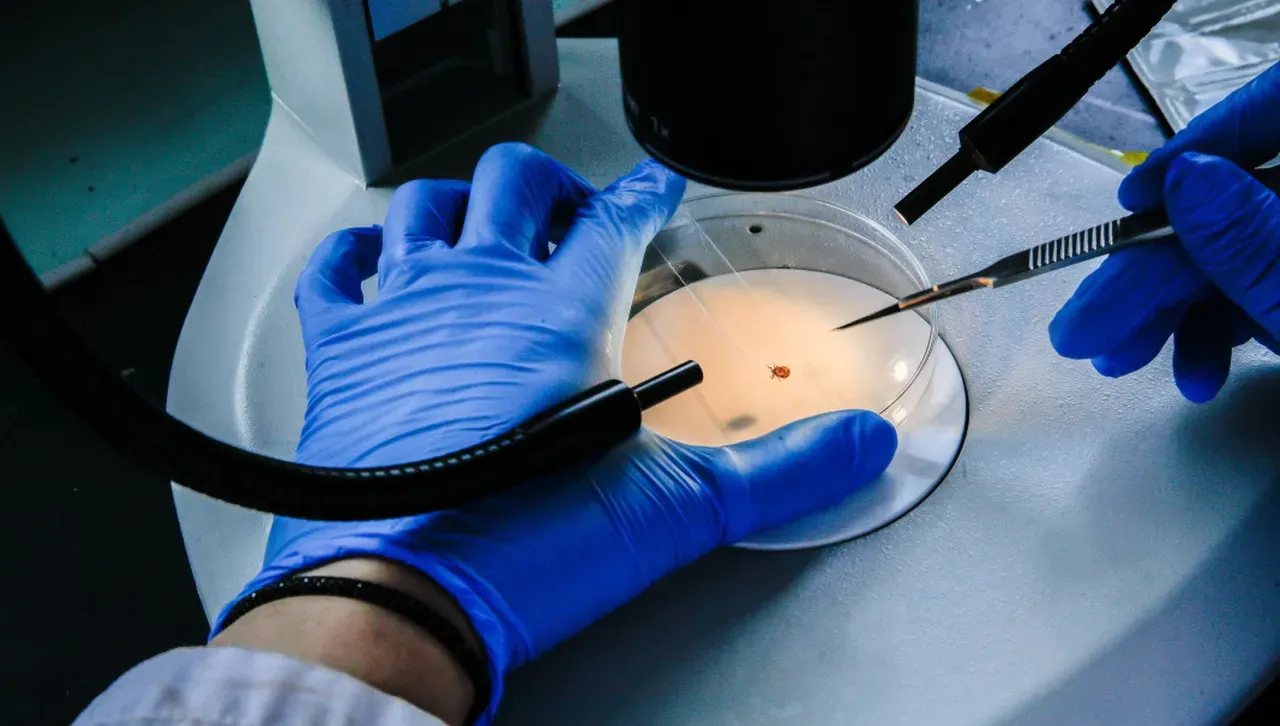
Американски изследователи: Високи дози витамин С убиват туморните клетки

Установено е, че витамин C наистина убива раковите клетки, особено зависимите от хормонални рецептори. Здравите клетки обаче остават резистентни дори при високи дози.
Изследователи от Технологичния институт на американския щат Джорджия са открили, че прилагането на високи дози витамин C може да забави растежа на раковите клетки, като същевременно здравите клетки остават относително невредими. Работата им е публикувана в списанието Cancers.
Жизнеспособността на клетките обикновено се тества с помощта на MTT/MTC анализи, при които специално багрило променя цвета си, ако клетката е активна. Самият витамин C обаче реагира с багрилото и изкривява картината, създавайки впечатление за прекомерна жизнеспособност.
За да се избегне тази грешка, екипът е използвал различен метод - PI/Triton X-100. Той използва пропидиев йодид - багрило, което прониква само в мъртвите клетки и се свързва с тяхната ДНК. Така е установено, че витамин C наистина убива туморните клетки, особено зависимите от хормонални рецептори.
Здравите клетки обаче остават резистентни дори при високи дози.
Учените подчертават, че в момента това са експерименти в епруветка.
В бъдеще витамин C може да се превърне в допълнение към стандартните лечения, но само с прецизен подбор на дозата и надеждни методи за мониторинг. /БГНЕС











Още от Наука
Астрономи откриха най-големите екзопланети, по-леки от памук
Те имат размерите на Юпитер, обикалят около звезда на повече от 1000 светлинни години разстояние и са открити от спътника TESS на НАСА
Учен: Времето не е вечно и един ден може да загуби смисъл
Може ли времето да изчезне? Ново изследване в областта на квантовата гравитация предполага, че времето не е фундаментална характеристика на Вселената. Според теорията то зависи от кривината на пространството и може постепенно да загуби значението си с разширяването на Космоса
INSAIT получи най-високото отличие на Европейския съвет за научни изследвания
За първи път българска научна институция е удостоена с такова отличие: "Постигнахме немислимото"